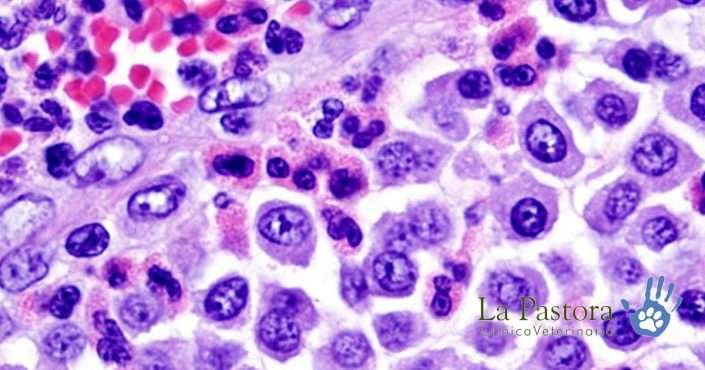

LABORATORIO VETERINARIO

De vital importancia para obtener un diagnóstico preciso para dar inicio al tratamiento más adecuado a diversas afecciones en los animales, los exámenes de laboratorio veterinario y de imágen son indicados de acuerdo con la evaluación clínica del médico veterinario y son realizadas en la propia clínica, o tomadas las muestras en nuestra clínica y enviadas a un laboratorio externo.
Muchas veces son necesarios varios exámenes de Laboratorio Veterinario para llegar a un diagnóstico concreto sobre lo que le sucede a tus mejores amigos.
EXÁMENES DE LABORATORIO
Diagnosticar a través de análisis clínicos de Laboratorio Veterinario, además de ser parte del procedimiento homologado de diagnóstico, se vuelve nuestra mejor herramienta para ser asertivos, ágiles y efectivos en el ofrecimiento de nuestros servicios, orientados a la identificación de la afección que aqueja los animales, así como en el desarrollo de un tratamiento para devolverles la salud.